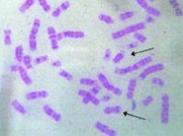
染色體異常

染色體是組成細胞核的基本物質(zhì),是基因的載體。染色體異常(chromosome abnormalities)也稱染色體發(fā)育不全(chromosome dysgenesis)。
美籍華人蔣有興(1956)查明人類染色體為46條,Caspersson等(1970)首次發(fā)表人類染色體顯帶照片。自1971年巴黎國際染色體命名會議以來,已發(fā)現(xiàn)人類染色體數(shù)目異常和結(jié)構(gòu)畸變3000余種,目前已確認染色體病綜合征100余種,智力低下和生長發(fā)育遲滯是染色體病的共同特征。